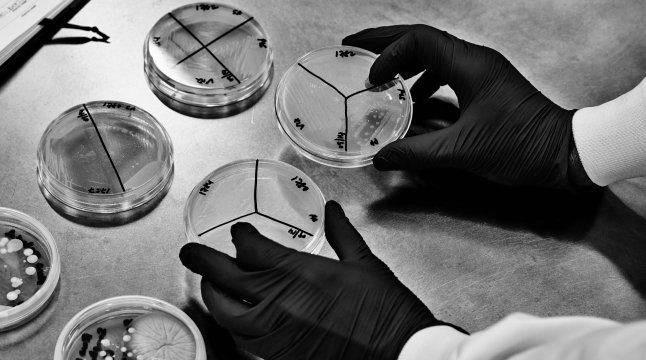

But AI, like any technology, is only as good as the intent and data behind it. The following are some important factors that should be considered to ensure AI in skincare is effective, ethical, and inclusive.
Bias in Data
Many AI skin tools have historically been trained on limited datasets, which can skew analysis toward lighter or only a certain segment of skin tones that have been published in literature.
Transparency & Control
Consumers deserve to know when AI is being used to influence their experience - whether it’s in product suggestions or formulations.
Environmental Impact of AI
The computational power required to train and operate large AI models is energy-intensive and carries its own carbon footprint. Like video streaming or cloud computing, each AI query consumes energy, and the environmental impact depends largely on the energy sources powering the data centers where that computation occurs.
For users in Canada, AI tools such as Google’s Gemini are typically routed through Google Cloud data centers located in Toronto or Montréal. These regions are supported by one of the cleanest electricity grids in the world, largely powered by low-carbon hydro and nuclear energy. Operating AI systems within these regions can reduce the carbon footprint per query by an estimated 10× to 200× compared to average U.S. or global facilities - even before factoring in Google’s renewable energy initiatives.
While DECIEM’s AI tools most likely run through these Canadian data centers, we recognize that workloads can shift to other centers based on capacity and network conditions. Gaining transparency from AI providers around data center locations and energy sourcing remains an important next step in understanding the full environmental impact of our digital operations.